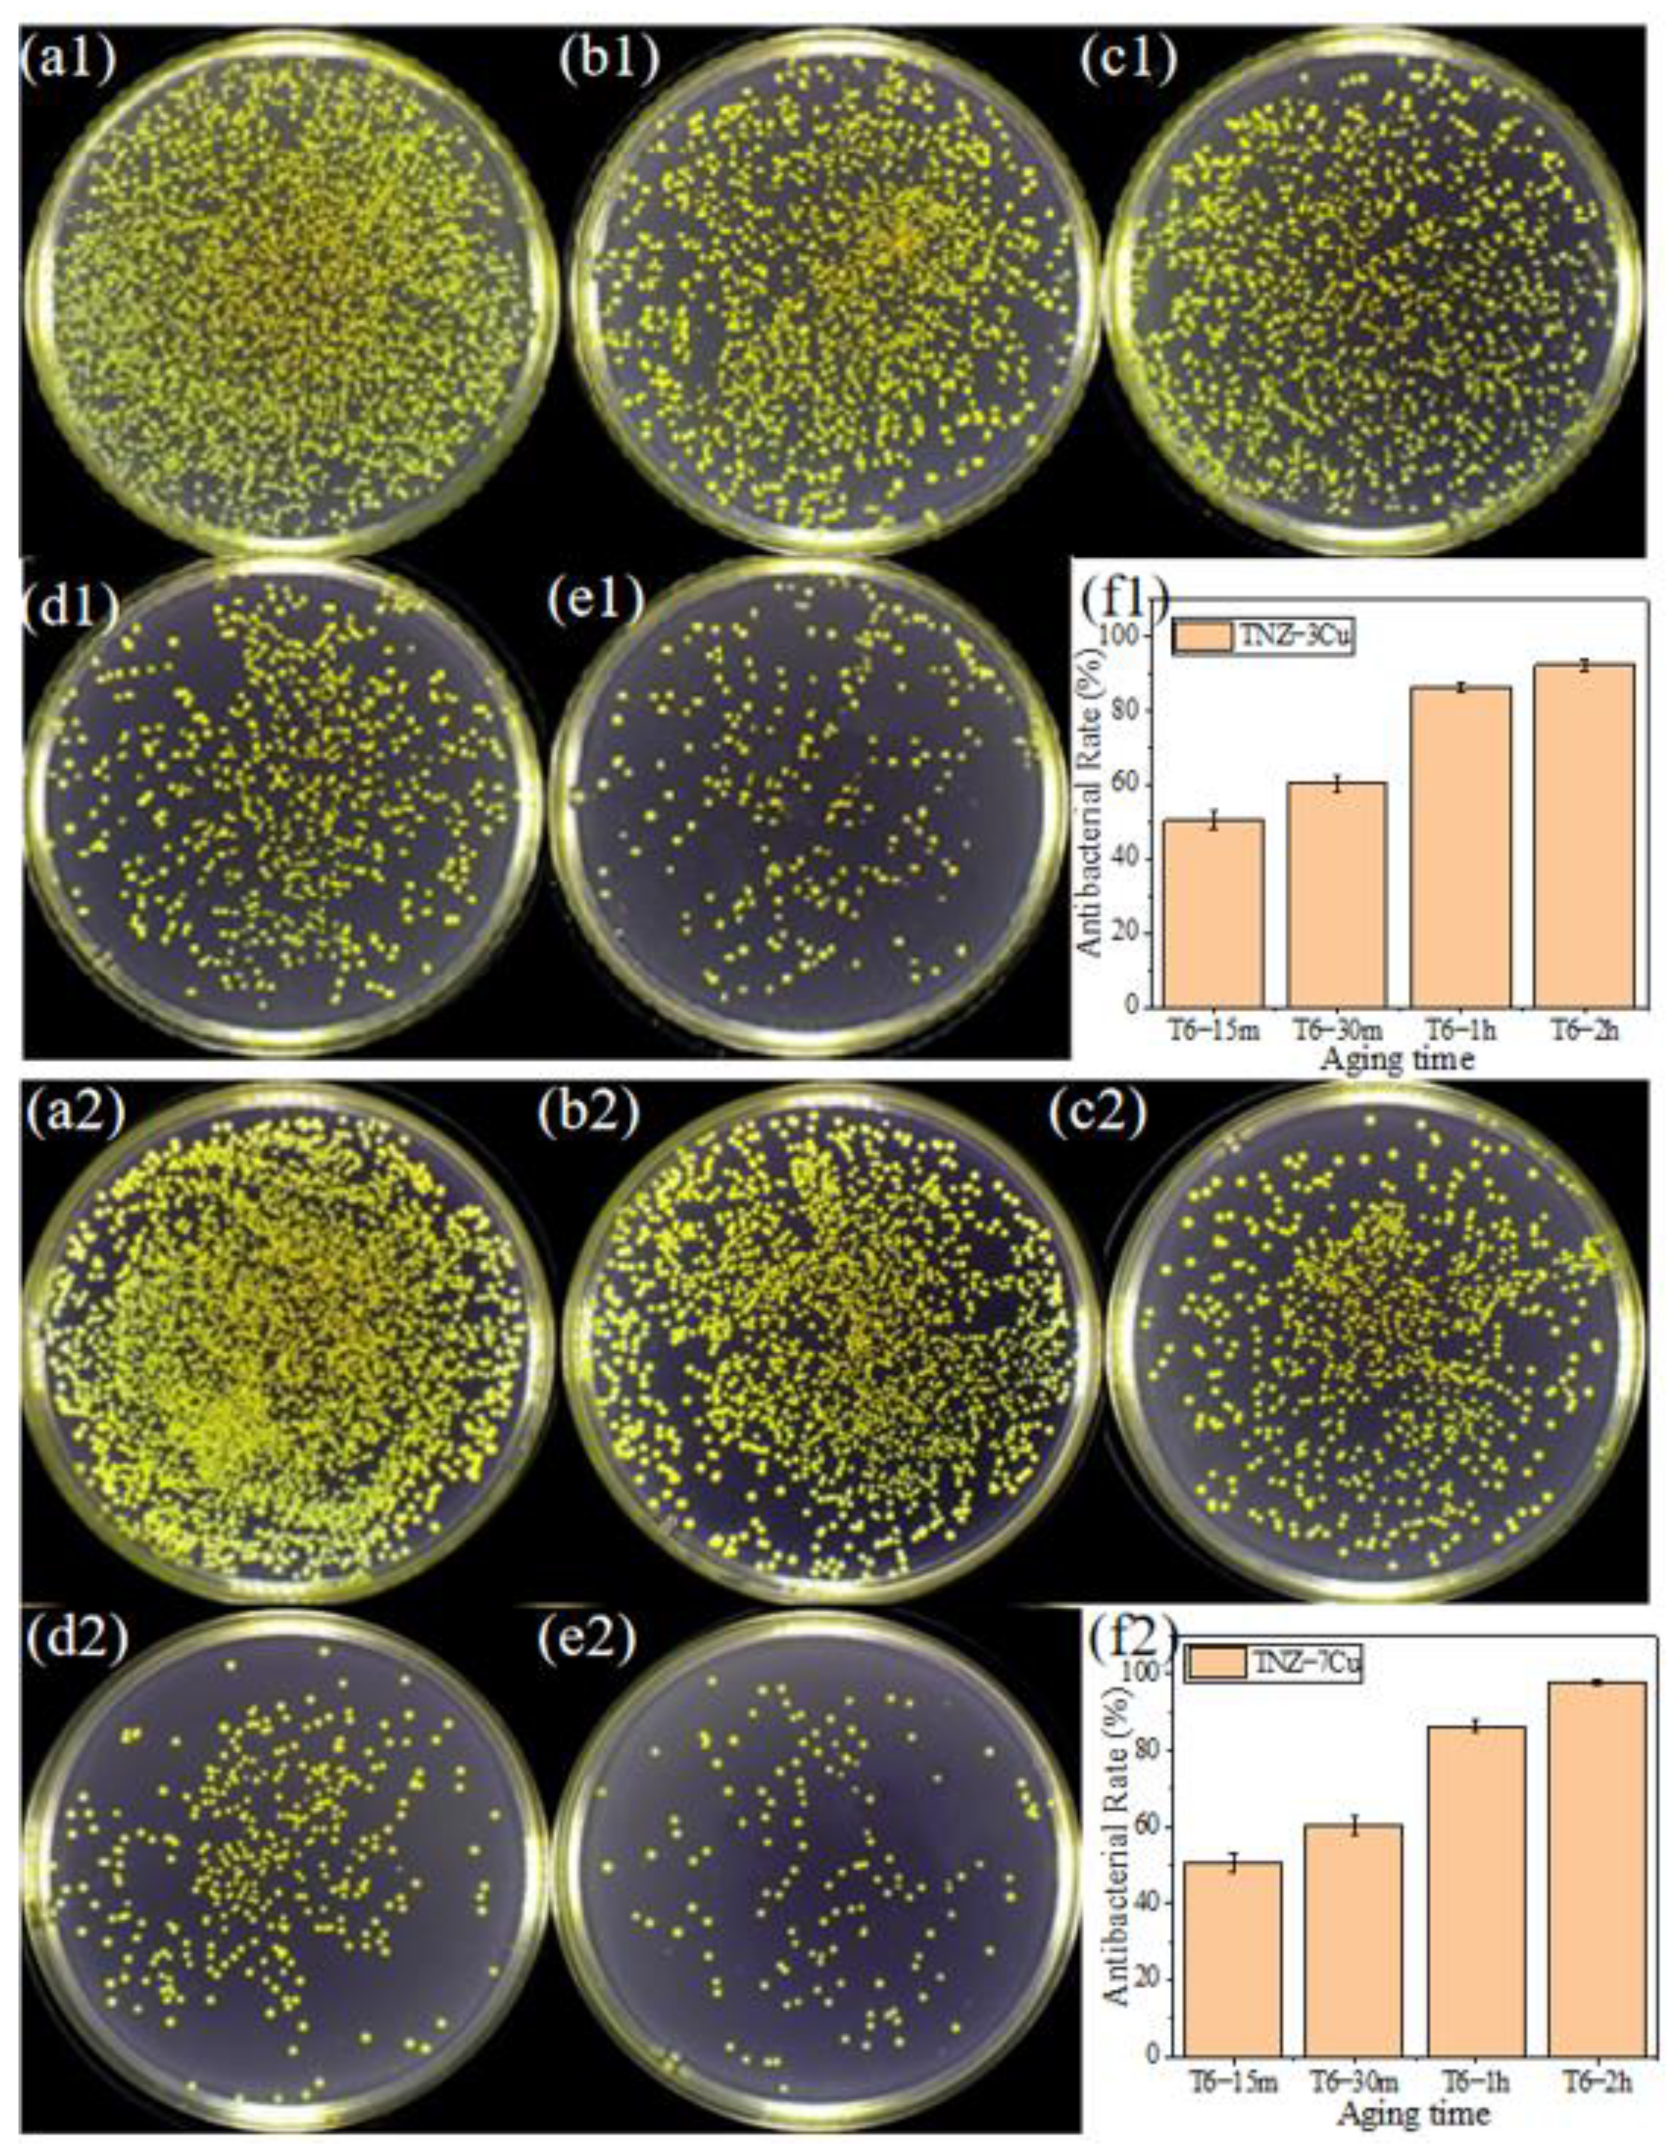
Metals 12 01132 g010

The Influence of Copper Content on the Elastic Modulus and Antibacterial Properties of Ti-13Nb-13Zr-xCu Alloy
Abstract
:1. Introduction
2. Experimental
2.1. Preparation of Materials
2.2. Microstructure Observation
2.3. Hardness and Elastic Modulus
2.4. Electrochemical Test
2.5. Ion Release
2.6. Antibacterial Properties
2.7. Live/Dead Staining
2.8. Morphology of the Bacteria
2.9. Cytotoxicity
2.10. Statistical Analysis
3. Results
3.1. Phase Constitution
3.2. Microstructure
3.3. Microhardness
3.4. Corrosion Property
3.5. Cu Ion Dissolution
3.6. Antibacterial Properties
3.7. Cell Cytotoxicity
3.8. Cell Adhesion Property
4. Discussion
4.1. Phase Transformation
4.2. Mechanical and Corrosion Properties
4.3. Antibacterial Properties
4.4. Biocompatibility
5. Conclusions
Author Contributions
Funding
Institutional Review Board Statement
Informed Consent Statement
Data Availability Statement
Conflicts of Interest
References
- Niinomi, M. Titanium Alloys. In Encyclopedia of Biomedical Engineering; Narayan, R., Ed.; Elsevier: Oxford, UK, 2019; pp. 213–224. [Google Scholar]
- Gerić, M.; Gajski, G.; Mihaljević, B.; Miljanić, S.; Domijan, A.-M.; Garaj-Vrhovac, V. Radioprotective properties of food colorant sodium copper chlorophyllin on human peripheral blood cells in vitro. Mutat. Res. Genet. Toxicol. Environ. Mutagenesis 2019, 845, 403027. [Google Scholar] [CrossRef] [PubMed]
- Xu, D.; Lu, Z.; Wang, T.; Wang, S.; Jiang, Y.; Xu, Z.; Bi, Z.; Geng, S. Novel Ti-based alloys prepared with different heat treatment strategies as antibacterial biomedical implants. Mater. Des. 2012, 205, 109756. [Google Scholar] [CrossRef]
- Baptista, C.A.R.P.; Schneider, S.G.; Taddei, E.B.; da Silva, H.M. Fatigue behavior of arc melted Ti–13Nb–13Zr alloy. Int. J. Fatigue 2004, 26, 967–973. [Google Scholar] [CrossRef]
- Kuroda, D.; Niinomi, M.; Morinaga, M.; Kato, Y.; Yashiro, T. Design and mechanical properties of new β type titanium alloys for implant materials. Mater. Sci. Eng. A 1998, 243, 244–249. [Google Scholar] [CrossRef]
- Zhang, Y.; Cui, S.; Cao, S.; Yang, L.; Qin, G.; Zhang, E. To improve the angiogenesis of endothelial cells on Ti-Cu alloy by the synergistic effects of Cu ions release and surface nanostructure. Surf. Coat. Technol. 2022, 433, 128116. [Google Scholar] [CrossRef]
- Shirai, T.; Watanabe, K.; Matsubara, H.; Nomura, I.; Fujiwara, H.; Arai, Y.; Ikoma, K.; Terauchi, R.; Kubo, T.; Tsuchiya, H. Prevention of pin tract infection with iodine-supported titanium pins. J. Orthop. Sci. 2014, 19, 598–602. [Google Scholar] [CrossRef] [Green Version]
- Ren, L.; Ma, Z.; Li, M.; Zhang, Y.; Liu, W.; Liao, Z.; Yang, K. Antibacterial Properties of Ti–6Al–4V–xCu Alloys. J. Mater. Sci. Technol. 2014, 30, 699–705. [Google Scholar] [CrossRef]
- Zhang, E.; Zheng, L.; Liu, J.; Bai, B.; Liu, C. Influence of Cu content on the cell biocompatibility of Ti–Cu sintered alloys. Mater. Sci. Eng. C 2015, 46, 148–157. [Google Scholar] [CrossRef]
- Shi, A.; Cai, D.; Hu, J.; Zhao, X.; Qin, G.; Han, Y.; Zhang, E. Development of a low elastic modulus and antibacterial Ti-13Nb-13Zr-5Cu titanium alloy by microstructure controlling. Mater. Sci. Eng. C 2021, 126, 112116. [Google Scholar] [CrossRef]
- Cai, D.; Zhao, X.; Yang, L.; Wang, R.; Qin, G.; Chen, D.-F.; Zhang, E. A novel biomedical titanium alloy with high antibacterial property and low elastic modulus. J. Mater. Sci. Technol. 2021, 81, 13–25. [Google Scholar] [CrossRef]
- Javadhesari, S.M.; Alipour, S.; Akbarpour, M.R. Biocompatibility, osseointegration, antibacterial and mechanical properties of nanocrystalline Ti-Cu alloy as a new orthopedic material. Colloids Surf. B Biointerfaces 2020, 189, 110889. [Google Scholar] [CrossRef] [PubMed]
- Duan, R.; Li, S.; Cai, B.; Zhu, W.; Ren, F.; Attallah, M.M. A high strength and low modulus metastable β Ti-12Mo-6Zr-2Fe alloy fabricated by laser powder bed fusion in-situ alloying. Addit. Manuf. 2021, 37, 101708. [Google Scholar] [CrossRef]
- Gerhard, W.; Boyer, R.R.; Collings, E.W. Materials Properties Handbook: Titanium Alloys. ASM International: Novelty, OH, USA, 1994. [Google Scholar]
- Zhang, W.; Zhang, S.; Liu, H.; Ren, L.; Wang, Q.; Zhang, Y. Effects of surface roughening on antibacterial and osteogenic properties of Ti-Cu alloys with different Cu contents. J. Mater. Sci. Technol. 2021, 88, 158–167. [Google Scholar] [CrossRef]
- Bao, M.; Liu, Y.; Wang, X.; Yang, L.; Li, S.; Ren, J.; Qin, G.; Zhang, E. Optimization of mechanical properties, biocorrosion properties and antibacterial properties of wrought Ti-3Cu alloy by heat treatment. Bioact. Mater. 2018, 3, 28–38. [Google Scholar] [CrossRef] [PubMed]
- Xi, T.; Shahzad, M.B.; Xu, D.; Zhao, J.; Yang, C.; Qi, M.; Yang, K. Copper precipitation behavior and mechanical properties of Cu-bearing 316L austenitic stainless steel: A comprehensive cross-correlation study. Mater. Sci. Eng. A 2016, 675, 243–252. [Google Scholar] [CrossRef]
- Thongsrikhem, N.; Taokaew, S.; Sriariyanun, M.; Kirdponpattara, S. Antibacterial activity in gelatin-bacterial cellulose composite film by thermally crosslinking with cinnamaldehyde towards food packaging application. Food Packag. Shelf Life 2022, 31, 100766. [Google Scholar] [CrossRef]
- Sun, K.; Yi, X.; Sun, B.; Yin, X.; Meng, X.; Cai, W.; Zhao, L. Microstructure and mechanical properties of Ti–V–Al–Cu shape memory alloy by tailoring Cu content. Mater. Sci. Eng. A 2020, 771, 138641. [Google Scholar] [CrossRef]
- Du, Z.; Guo, H.; Liu, J.; Cheng, J.; Zhao, X.; Wang, X.; Liu, F.; Cui, X. Microstructure evolution during aging heat treatment and its effects on tensile properties and dynamic Young’s modulus of a biomedical β titanium alloy. Mater. Sci. Eng. A 2020, 791, 139677. [Google Scholar] [CrossRef]
- Amigó-Borrás, V.; Lario-Femenía, J.; Amigó-Mata, A.; Vicente-Escuder, Á. Titanium, Titanium Alloys and Composites. In Encyclopedia of Materials: Metals and Alloys; Caballero, F.G., Ed.; Elsevier: Oxford, UK, 2022; pp. 179–199. [Google Scholar]
- Kumar, P.; Mahobia, G.S.; Mandal, S.; Singh, V.; Chattopadhyay, K. Enhanced corrosion resistance of the surface modified Ti-13Nb-13Zr alloy by ultrasonic shot peening. Corros. Sci. 2021, 189, 109597. [Google Scholar] [CrossRef]
- Jin, X.; Gao, L.; Liu, E.; Yu, F.; Shu, X.; Wang, H. Microstructure, corrosion and tribological and antibacterial properties of Ti–Cu coated stainless steel. J. Mech. Behav. Biomed. Mater. 2015, 50, 23–32. [Google Scholar] [CrossRef] [Green Version]
- Chen, M.; Yang, L.; Zhang, L.; Han, Y.; Lu, Z.; Qin, G.; Zhang, E. Effect of nano/micro-Ag compound particles on the bio-corrosion, antibacterial properties and cell biocompatibility of Ti-Ag alloys. Mater. Sci. Eng. C 2017, 75, 906–917. [Google Scholar] [CrossRef]
- Zhang, E.; Zhao, X.; Hu, J.; Wang, R.; Fu, S.; Qin, G. Antibacterial metals and alloys for potential biomedical implants. Bioact. Mater. 2021, 6, 2569–2612. [Google Scholar] [CrossRef] [PubMed]
- Hu, N.; Xie, L.; Liao, Q.; Gao, A.; Zheng, Y.; Pan, H.; Tong, L.; Yang, D.; Gao, N.; Starink, M.J.; et al. A more defective substrate leads to a less defective passive layer: Enhancing the mechanical strength, corrosion resistance and anti-inflammatory response of the low-modulus Ti-45Nb alloy by grain refinement. Acta Biomater. 2021, 126, 524–536. [Google Scholar] [CrossRef] [PubMed]
- Ke, Z.; Yi, C.; Zhang, L.; He, Z.; Tan, J.; Jiang, Y. Characterization of a new Ti-13Nb-13Zr-10Cu alloy with enhanced antibacterial activity for biomedical applications. Mater. Lett. 2019, 253, 335–338. [Google Scholar] [CrossRef]
- Cui, S.; Liu, S.; Nie, J.; Chen, D.; Wu, X.; Qin, G.; Zhang, E. Design and preparation of a biomedical titanium alloy with low elastic modulus and high antibacterial property based on Ti-Mo-Ag system. J. Alloys Compd. 2022, 908, 164639. [Google Scholar] [CrossRef]
- Burghardt, I.; Lüthen, F.; Prinz, C.; Kreikemeyer, B.; Zietz, C.; Neumann, H.-G.; Rychly, J. A dual function of copper in designing regenerative implants. Biomaterials 2015, 44, 36–44. [Google Scholar] [CrossRef]
- Yang, J.; Qin, H.; Chai, Y.; Zhang, P.; Chen, Y.; Yang, K.; Qin, M.; Zhang, Y.; Xia, H.; Ren, L.; et al. Molecular mechanisms of osteogenesis and antibacterial activity of Cu-bearing Ti alloy in a bone defect model with infection in vivo. J. Orthop. Transl. 2021, 27, 77–89. [Google Scholar] [CrossRef]
- Xia, C.; Ma, X.; Zhang, X.; Li, K.; Tan, J.; Qiao, Y.; Liu, X. Enhanced physicochemical and biological properties of C/Cu dual ions implanted medical titanium. Bioact. Mater. 2020, 5, 377–386. [Google Scholar] [CrossRef] [PubMed]
- Fu, S.; Zhang, Y.; Yang, Y.; Liu, X.; Zhang, X.; Yang, L.; Xu, D.; Wang, F.; Qin, G.; Zhang, E. An antibacterial mechanism of titanium alloy based on micro-area potential difference induced reactive oxygen species. J. Mater. Sci. Technol. 2022, 119, 75–86. [Google Scholar] [CrossRef]
- Lu, M.; Zhang, Z.; Zhang, J.; Wang, X.; Qin, G.; Zhang, E. Enhanced antibacterial activity of Ti-Cu alloy by selective acid etching. Surf. Coat. Technol. 2021, 421, 127478. [Google Scholar] [CrossRef]
- Ren, L.; Xu, X.; Liu, H.; Yang, K.; Qi, X. Biocompatibility and Cu ions release kinetics of copper-bearing titanium alloys. J. Mater. Sci. Technol. 2021, 95, 237–248. [Google Scholar] [CrossRef]
- Zhang, E.; Li, F.; Wang, H.; Liu, J.; Wang, C.; Li, M.; Yang, K. A new antibacterial titanium–copper sintered alloy: Preparation and antibacterial property. Mater. Sci. Eng. C 2013, 33, 4280–4287. [Google Scholar] [CrossRef] [PubMed]
- Lucke, M.; Schmidmaier, G.; Sadoni, S.; Wildemann, B.; Schiller, R.; Haas, N.P.; Raschke, M. Gentamicin coating of metallic implants reduces implant-related osteomyelitis in rats. Bone 2003, 32, 521–531. [Google Scholar] [CrossRef]
- Chen, M.; Wang, X.-Q.; Zhang, E.-L.; Wan, Y.-Z.; Hu, J. Antibacterial ability and biocompatibility of fluorinated titanium by plasma-based surface modification. Rare Met. 2022, 41, 689–699. [Google Scholar] [CrossRef]
- Stigter, M.; Bezemer, J.; de Groot, K.; Layrolle, P. Incorporation of different antibiotics into carbonated hydroxyapatite coatings on titanium implants, release and antibiotic efficacy. J. Control. Release 2004, 99, 127–137. [Google Scholar] [CrossRef]
- Cao, S.; Zhang, Z.-M.; Zhang, J.-Q.; Wang, R.-X.; Wang, X.-Y.; Yang, L.; Chen, D.-F.; Qin, G.-W.; Zhang, E.-L. Improvement in antibacterial ability and cell cytotoxicity of Ti–Cu alloy by anodic oxidation. Rare Met. 2022, 41, 594–609. [Google Scholar] [CrossRef]

| Alloys | T4 | T6-15m | T6-30m | T6-1h | T6-2h |
|---|---|---|---|---|---|
| TNZ-3Cu | α′′ + β | α + α′′ + β (reduce) | α + α′′ + β (remain) | α + α′′ + β | α + α′′ + β + Ti2Cu |
| TNZ-7Cu | α′′ + β | α + α′′ + β + Ti2Cu | α + α′′ + β + Ti2Cu | α + α′′ + β + Ti2Cu | α + α′′ + β + Ti2Cu |
| Samples | Ecorr (V) | icorr (A/cm2) | Eocp (V) |
|---|---|---|---|
| cp-Ti | −0.327 ± 0.019 | (5.122 ± 2.9) × 10−8 | −0.297 ± 0.029 |
| TNZ-3Cu(T4) | −0.394 ± 0.017 | (1.102 ± 2.3) × 10−8 | −0.255 ± 0.018 |
| TNZ-3Cu(T6-30m) | −0.337 ± 0.056 | (1.787 ± 4.1) × 10−8 | −0.324 ± 0.031 |
| TNZ-3Cu(T6-2h) | −0.338 ± 0.027 | (1.494 ± 5.5) × 10−8 | −0.327 ± 0.011 |
| TNZ-7Cu(T4) | −0.340 ± 0.029 | (1.102 ± 4.9) × 10−8 | −0.320 ± 0.019 |
| TNZ-7Cu(T6-30m) | −0.119 ± 0.019 | (4.997 ± 4.9) × 10−7 | −0.095 ± 0.016 |
| TNZ-7Cu(T6-2h) | −0.114 ± 0.031 | (7.733 ± 2.2) × 10−7 | −0.104 ± 0.019 |
Publisher’s Note: MDPI stays neutral with regard to jurisdictional claims in published maps and institutional affiliations. |
© 2022 by the authors. Licensee MDPI, Basel, Switzerland. This article is an open access article distributed under the terms and conditions of the Creative Commons Attribution (CC BY) license (https://creativecommons.org/licenses/by/4.0/).
Share and Cite
Mao, X.; Shi, A.; Wang, R.; Nie, J.; Qin, G.; Chen, D.; Zhang, E. The Influence of Copper Content on the Elastic Modulus and Antibacterial Properties of Ti-13Nb-13Zr-xCu Alloy. Metals 2022, 12, 1132. https://doi.org/10.3390/met12071132
Mao X, Shi A, Wang R, Nie J, Qin G, Chen D, Zhang E. The Influence of Copper Content on the Elastic Modulus and Antibacterial Properties of Ti-13Nb-13Zr-xCu Alloy. Metals. 2022; 12(7):1132. https://doi.org/10.3390/met12071132
Chicago/Turabian StyleMao, Xinru, Anqi Shi, Renxian Wang, Jingjun Nie, Gaowu Qin, Dafu Chen, and Erlin Zhang. 2022. "The Influence of Copper Content on the Elastic Modulus and Antibacterial Properties of Ti-13Nb-13Zr-xCu Alloy" Metals 12, no. 7: 1132. https://doi.org/10.3390/met12071132
APA StyleMao, X., Shi, A., Wang, R., Nie, J., Qin, G., Chen, D., & Zhang, E. (2022). The Influence of Copper Content on the Elastic Modulus and Antibacterial Properties of Ti-13Nb-13Zr-xCu Alloy. Metals, 12(7), 1132. https://doi.org/10.3390/met12071132

